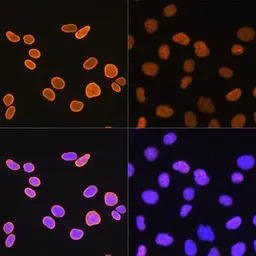
产品细节图片2
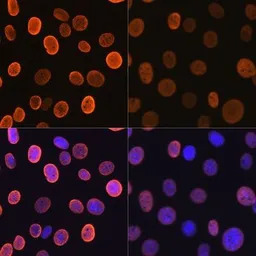
产品细节图片3

相关产品推荐更多 >
万千商家帮你免费找货
0 人在求购买到急需产品
- 详细信息
- 文献和实验
- 技术资料
- 免疫原:
A synthesized peptide derived from hmuan Histone H4 (acetyl K5)
- 亚型:
IgG
- 形态:
Liquid
- 保存条件:
Store as concentrated solution. Centrifuge briefly prior to opening vial. For short-term storage (1-2 weeks), store at 4ºC. For long-term storage, aliquot and store at -20ºC or below. Avoid multiple freeze-thaw cycles.
- 克隆性:
Monoclonal
- 标记物:
Unconjugated
- 适应物种:
Human, Mouse, Rat
- 保质期:
12 months from the shipping date of the product.
- 抗原来源:
Human
- 目录编号:
GTX00775
- 级别:
Primary Antibodies
- 库存:
Available
- 供应商:
GeneTex
- 宿主:
Rabbit
- 应用范围:
WB, ICC/IF, IHC-P
- 浓度:
Batch dependent (Please refer to the vial label for the specific concentration.)
- 靶点:
Histone H4K5ac (acetyl Lys5)
- 抗体英文名:
Histone H4K5ac (acetyl Lys5) antibody [GT1138]
- 抗体名:
Histone H4K5ac (acetyl Lys5) 抗体 [GT1138]
- 规格:
100 μl

Untreated (–) and treated (+) HeLa whole cell extracts (30 μg) were separated by 15% SDS-PAGE, and the membrane was blotted with Histone H4K5ac (acetyl Lys5) antibody [GT1138] (GTX00775) diluted at 1:500. The HRP-conjugated anti-rabbit IgG antibody (GTX213110-01) was used to detect the primary antibody.
ICC/IF analysis of U2OS cells treated with/without TSA (1 μM at 37ºC for 18 hours) using GTX00775 Histone H4K5ac (acetyl Lys5) antibody [GT1138].
Orange: Primary antibody
Blue: DAPI
ICC/IF analysis of NIH3T3 cells treated with/without TSA (1 μM at 37ºC for 18 hours) using GTX00775 Histone H4K5ac (acetyl Lys5) antibody [GT1138].
Orange: Primary antibody
Blue: DAPI

IHC-P analysis of rat brain tissue section using GTX00775 Histone H4K5ac (acetyl Lys5) antibody [GT1138].
Dlution : 1:100

IHC-P analysis of mouse kidney tissue section using GTX00775 Histone H4K5ac (acetyl Lys5) antibody [GT1138].
Dlution : 1:100

IHC-P analysis of hmuan appendix tissue section using GTX00775 Histone H4K5ac (acetyl Lys5) antibody [GT1138].
Dlution : 1:100

WB analysis of HeLa and C6 whole cell lysates using GTX00775 Histone H4K5ac (acetyl Lys5) antibody [GT1138].
Dilution : 1:1000
Loading : 25μg

ICC/IF analysis of C6 cells treated with/without TSA (1 μM at 37ºC for 18 hours) using GTX00775 Histone H4K5ac (acetyl Lys5) antibody [GT1138].
Orange: Primary antibody
Blue: DAPI
风险提示:丁香通仅作为第三方平台,为商家信息发布提供平台空间。用户咨询产品时请注意保护个人信息及财产安全,合理判断,谨慎选购商品,商家和用户对交易行为负责。对于医疗器械类产品,请先查证核实企业经营资质和医疗器械产品注册证情况。
 文献和实验
文献和实验,为此CST公司推出了可用于蛋白功能检测的乙酰化组蛋白系列抗体,圆满的解决这个问题。因为乙酰化与蛋白的活性相关,因此通过乙酰化的系列抗体特异性地识别靶蛋白的乙酰化形式,可以反映出靶蛋白质的活性水平,达到研究蛋白功能和调节的目的。而其他的抗体仅能反映出该蛋白质的表达量或表达水平,不能反映出蛋白的活性状态。乙酰化系列抗体:Catalog#Product DescriptionSourceApplications2576Acetyl-Histone H2A (Lys5) AntibodyRabbitW IP
Identifying Acetylated Proteins in Mitosis
the acetylation status of several mitotic proteins by anti-acetyl-Lysine immunoprecipitation with a monoclonal antibody followed by Western blot analyses of the proteins of interest. We further confirmed by a reciprocal immunoprecipitation with protein-specific
from the antibody-bound and antibody-unbound fractions (from Chromatin Immunoprecipitation on Unfixed Chromatin from Cells and Tissues to Analyze Histone Modifications). Control genomic DNA should be used as well. For each PCR reaction, we use 20-50 ng of template
 技术资料
技术资料暂无技术资料 索取技术资料






![NKp46 antibody [N1C3]](https://img1.dxycdn.com/2023/0516/045/6925717576889828561-14.jpg!wh200)
![HCK antibody [3D12E10]](https://img1.dxycdn.com/2023/0711/451/6106825198874858761-14.jpg!wh200)

